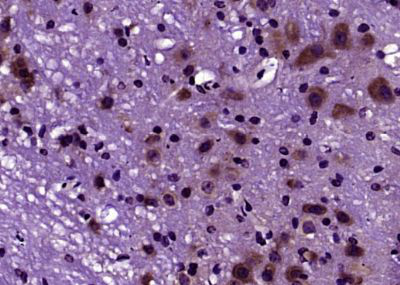
产品细节图片1

相关产品推荐更多 >
万千商家帮你免费找货
0 人在求购买到急需产品
- 详细信息
- 文献和实验
- 技术资料
- 供应商:
江西江蓝纯生物试剂有限公司
- 库存:
46
- 克隆性:
单克隆
- 保质期:
1年
- 抗体英文名:
DNase II
- 抗体名:
脱氧核糖核酸酶2抗体
- 适应物种:
人/动物/植物
- 应用范围:
WB,ELISA等
- 浓度:
1mg/ml
- 保存条件:
-20 °
- 规格:
100ul/200ul
| 规格: | 100ul | 产品价格: | ¥1580.0 |
|---|---|---|---|
| 规格: | 200ul | 产品价格: | ¥2480.0 |
英文名称 : DNase II
中文名称 : 脱氧核糖核酸酶2抗体
别 名 : Acid DNase; Deoxyribonuclease 2 alpha; Deoxyribonuclease 2; Deoxyribonuclease II alpha; Deoxyribonuclease II; Deoxyribonuclease II lysosomal; Deoxyribonuclease-2-alpha; Deoxyribonuclease2; DeoxyribonucleaseII; DNASE 2; DNASE 2A; DNase II alpha; DNase II lysosomal; DNASE2; DNASE2A; DNaseII; DNL 2; DNL; DNL2; DNS2A_HUMAN; Lysosomal DNase II; R31240 2; R31240_2.
研究领域 : 细胞生物 细胞凋亡 细胞周期蛋白 表观遗传学
抗体来源 : Rabbit
克隆类型 : Polyclonal
交叉反应 : Human, Mouse, Rat, Dog, Pig, Cow, Sheep,
产品应用 : ELISA=1:500-1000 IHC-P=1:400-800 IF=1:100-500 (石蜡切片需做抗原修复)
not yet tested in other applications.
optimal dilutions/concentrations should be determined by the end user.
分 子 量 : 38kDa
细胞定位 : 细胞浆
性 状 : Lyophilized or Liquid
浓 度 : 1mg/ml
免 疫 原 : KLH conjugated synthetic peptide derived from human DNase II:25-90/360
亚 型 : IgG
纯化方法 : affinity purified by Protein A
储 存 液 : 0.01M TBS(pH7.4) with 1% BSA, 0.03% Proclin300 and 50% Glycerol.
保存条件 : Store at -20 °C for one year. Avoid repeated freeze/thaw cycles. The lyophilized antibody is stable at room temperature for at least one month and for greater than a year when kept at -20°C. When reconstituted in sterile pH 7.4 0.01M PBS or diluent of antibody the antibody is stable for at least two weeks at 2-4 °C.
PubMed : PubMed
产品介绍 : Hydrolyzes DNA under acidic conditions with a preference for double-stranded DNA. Plays a major role in the degradation of nuclear DNA in cellular apoptosis during development. Necessary for proper fetal development and for definitive erythropoiesis in fetal liver, where it degrades nuclear DNA expelled from erythroid precursor cells.
Function:
Hydrolyzes DNA under acidic conditions with a preference for double-stranded DNA. Plays a major role in the degradation of nuclear DNA in cellular apoptosis during development. Necessary for proper fetal development and for definitive erythropoiesis in fetal liver, where it degrades nuclear DNA expelled from erythroid precursor cells.
Subcellular Location:
Lysosome.
Post-translational modifications:
Glycosylated. Mutations that eliminate N-glycosylation sites reduce activity, but enzymatic deglycosylation has no effect.
Similarity:
Belongs to the DNase II family.
SWISS:
O00115
Gene ID:
1777
Important Note:
This product as supplied is intended for research use only, not for use in human, therapeutic or diagnostic applications.
产品图片
风险提示:丁香通仅作为第三方平台,为商家信息发布提供平台空间。用户咨询产品时请注意保护个人信息及财产安全,合理判断,谨慎选购商品,商家和用户对交易行为负责。对于医疗器械类产品,请先查证核实企业经营资质和医疗器械产品注册证情况。
 文献和实验
文献和实验人抗磷脂酶A2抗体(Anti-PLA2R)酶联免疫分析(ELISA)
人 抗磷脂酶 A2 抗体( Anti-PLA2R ) 酶联免疫分析( ELISA ) 试剂盒使用说明书 本试剂盒仅供研究使用。 使用目的: 本试剂盒用于测定人血清,血浆及相关液体样本中 抗磷脂酶 A2 抗体( Anti-PLA2R ) 含量。 实验原理 本试剂盒应用间接法测定标本中人 抗磷脂酶 A2 抗体( Anti-PLA2R ) 水平。用纯化的抗原包被微孔板,制成固相抗原,往包被单抗的微孔
人乙型肝炎病毒前S2抗体(HBV preS2Ab)酶联免疫分析
人 乙型肝炎病毒前S2抗体(HBV preS2Ab) 酶联免疫 分析( ELISA ) 试剂 盒使用说明书 本试剂仅供研究使用 目的:本试剂盒用于测定人血清,血浆,组织液及相关液体样本中 乙型肝炎病毒前S2抗体(HBV preS2Ab)的 含量。 实验原理 : 本试剂盒应用双 抗原 夹心法测定 标本 中 人 乙型肝炎病毒前S2 抗体 (HBV preS2Ab) 水平。用纯化的 抗原 包被微孔板,制成固相 抗原 ,往包被单抗的微孔中依次
·1、目的 用于体外、肉眼观察、定性的免疫分析,监测血清或血浆中的HIV-1和HIV-2抗体,用于帮助测受感染个体的HIV-1和HIV-2抗体。本品测阳性者,需进一步确证。 2、原理 利用双抗原夹心法测HIV抗体。标本加入反应板,若标本中含有HIV抗体时,先与金标抗原反应,形成抗体-金标抗体复合物,在虹吸作用下向前移动,遇到包被抗原形成抗原-抗体-金标抗原复合物,并出现红色沉淀线。包被膜上同时有一条质控包被线作为对照,所以当出现一条红色质控线和一条(或两条)红色反应线时判断
 技术资料
技术资料暂无技术资料 索取技术资料










